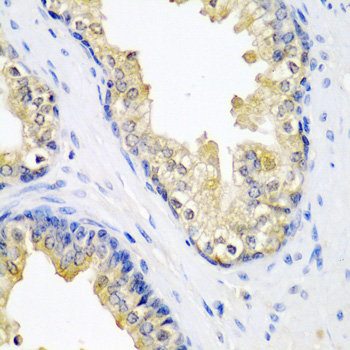

SPINT2 / HAI-2 Antibody (aa91-140)
LS-C135510
ApplicationsWestern Blot
Product group Antibodies
TargetSPINT2
Overview
- SupplierLifeSpan BioSciences
- Product NameSPINT2 / HAI-2 Antibody (aa91-140)
- Delivery Days Customer14
- Application Supplier NoteWestern Blot: Suggested dilution at 1 ug/ml in 5% skim milk / PBS buffer, and HRP conjugated anti-Rabbit IgG should be diluted in 1: 50,000 - 100,000 as secondary antibody.
- ApplicationsWestern Blot
- Applications SupplierWB (0.2 - 1 µg/ml) Western Blot: Suggested dilution at 1 ug/ml in 5% skim milk / PBS buffer, and HRP conjugated anti-Rabbit IgG should be diluted in 1: 50,000 - 100,000 as secondary antibody.
- CertificationResearch Use Only
- ClonalityPolyclonal
- Concentration0.5 mg/ml
- ConjugateUnconjugated
- Estimated Purity...
- Gene ID10653
- Target nameSPINT2
- Target descriptionserine peptidase inhibitor, Kunitz type 2
- Target synonymsDIAR3; HAI2; HAI-2; hepatocyte growth factor activator inhibitor type 2; Kop; kunitz-type protease inhibitor 2; PB; serine protease inhibitor, Kunitz type, 2; testicular tissue protein Li 183
- HostRabbit
- Storage Instruction-20°C,2°C to 8°C
- UNSPSC12352203

![Various whole cell extracts (30 microg) were separated by 12% SDS-PAGE, and the membrane was blotted with HAI-2 antibody [DC16] (GTX02800) diluted at 1:1000. The HRP-conjugated anti-mouse IgG antibody (GTX213111-01) was used to detect the primary antibody.](https://www.genetex.com/upload/website/prouct_img/normal/GTX02800/GTX02800_20201204_WB_w_23053122_846.webp)